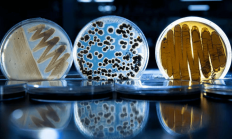
紫燕食品：已委托多家权威第三方检测机构对产品进行微生物检测

- 【美股盘前】三大期指涨跌不一;台积电盘前涨近2%;特斯拉美国市占率首次跌破50%;苹果微软放弃OpenAI董事会观察员席位
- 大盘高开低走,但多只布局机器人概念的基金逆势领涨
- 【美股盘前】三大期指齐涨,索尼涨超3%;瑞银将英伟达目标价从120美元上调至150美元;债基2024上半年“狂揽”近4000亿美元
-
维护资本市场“三公”秩序 监管机构持续强化并购重组内幕交易防控
-
人保车险|第三者责任险的作用是什么?如何购买?
-
人保车险|车辆损失险的保障范围是什么?
-
上证科创板创新药指数等3条指数正式发布
- 又有中小公募收缩直销战线;45只基金将在今年最后一个月发售
-
天有为主板IPO过会
-
紫燕食品:已委托多家权威第三方检测机构对产品进行微生物检测
 星际财经网
星际财经网